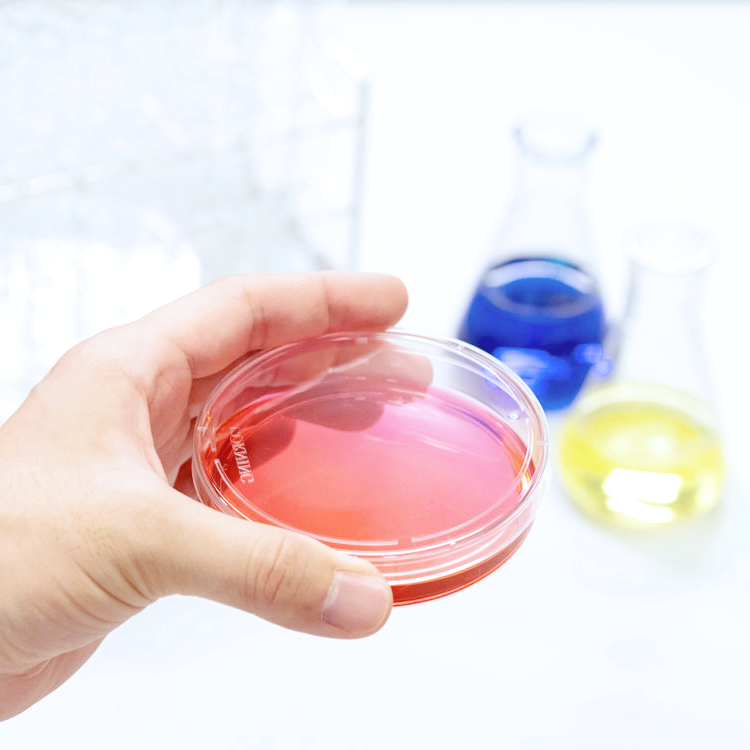

マイストア
変更
お店で受け取る
(送料無料)
配送する
納期目安:
2025.09.28 10:10頃のお届け予定です。
決済方法が、クレジット、代金引換の場合に限ります。その他の決済方法の場合はこちらをご確認ください。
※土・日・祝日の注文の場合や在庫状況によって、商品のお届けにお時間をいただく場合がございます。
富士薬品 ロコプレミアム7セット 楊・W・B 株式会社富士薬品の詳細情報
楊・W・B 株式会社富士薬品。セイムス」富士薬品グループのドラッグストア2024年3月1日。事業・製品情報 | 富士フイルム和光純薬株式会社。フジコン ワイドカップ バイオゼリーPRO 16g×50個: サンドラッグ。新品未開封ですので宜しくお願い致します♪
ベストセラーランキングです
近くの売り場の商品
カスタマーレビュー
オススメ度 4.9点
現在、2749件のレビューが投稿されています。